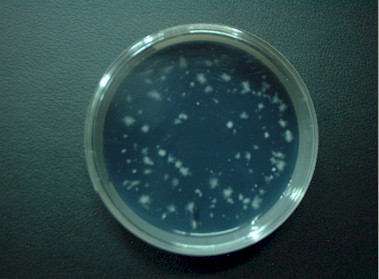

新入荷
再入荷
人気特価激安 Amazon.co.jp: 殺菌線スリッパロッカー DM-HR(455X515X1790MM その他
 タイムセール
タイムセール
終了まで
00
00
00
999円以上お買上げで送料無料(※)
999円以上お買上げで代引き手数料無料
999円以上お買上げで代引き手数料無料
通販と店舗では販売価格や税表示が異なる場合がございます。また店頭ではすでに品切れの場合もございます。予めご了承ください。
商品詳細情報
| 管理番号 |
新品 :19515199956
中古 :19515199956-1 |
メーカー | 35dd1b | 発売日 | 2025-04-17 18:21 | 定価 | 23800円 | ||
|---|---|---|---|---|---|---|---|---|---|
| カテゴリ | |||||||||
人気特価激安 Amazon.co.jp: 殺菌線スリッパロッカー DM-HR(455X515X1790MM その他
 Amazon.co.jp: 殺菌線スリッパロッカー DM-HR(455X515X1790MM,
Amazon.co.jp: 殺菌線スリッパロッカー DM-HR(455X515X1790MM, 殺菌線スリッパロッカー ゼンマイ式タイマー付 殺菌線保管庫 01,
殺菌線スリッパロッカー ゼンマイ式タイマー付 殺菌線保管庫 01, 8-5823-01 殺菌灯付きスリッパロッカー 650×450×1365mm DM-HS,
8-5823-01 殺菌灯付きスリッパロッカー 650×450×1365mm DM-HS, 殺菌線スリッパロッカー - 大信工業株式会社,
殺菌線スリッパロッカー - 大信工業株式会社, TGK - 東京硝子器械 TryWinZ / スリッパ殺菌線ロッカー DM-SLTW
TGK - 東京硝子器械 TryWinZ / スリッパ殺菌線ロッカー DM-SLTWSHARP ドラム式プラズマクラスター洗濯乾燥機(7㎏)
さわちん【送料無料】 令和6年産 新米『ひとめぼれ』10 Kg



























